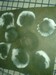

|
Saturday, February 7
|
View Page
|
 |
Received seed pack this week from scga.Thanks Joe!Now the hard part is deciding starting line up.
|
|
|
Saturday, February 7
|
View Page
|
 |
Started three of my 147 2013 (877 hunt x open) squash seeds today.Doing a test to see how green. Man! cabin fever is setting in. lol.
In the mail I have coming 1421 jutras,906 beaucheman,and 1237 pingrey.
|
|
|
Saturday, February 7
|
View Page
|
 |
In front is 1037 Jarvis x self. 506 lbs. 2014. Biggest I ever grew. Made the mistake of growing two on one plant...in back is 476lbs.Just wanted to make sure I at least got one squash.
Seeds are still inside. Not happy with colour.
|
|
|
Saturday, February 14
|
View Page
|
 |
Looks like someone got a hair cut while I was at work.
|
|
|
Saturday, February 14
|
View Page
|
 |
Coldest day of the year and Freddy got scissored.
|
|
|
Saturday, February 14
|
View Page
|
 |
I could really glow for you! Happy Valentines!
|
|
|
Sunday, February 15
|
View Page
|
 |
Happy Birthday to our flag! 50 today.
|
|
|
Sunday, February 15
|
View Page
|
 |
147 squash... three for three
|
|
|
Sunday, February 15
|
View Page
|
 |
Received squash seeds this week from NHGPGA. Lots to choose from. Thanks Steve!
|
|
|
Sunday, February 15
|
View Page
|
 |
Minus 43 last night with wind chill. Sun is getting stronger.Tomorrow looks better. Good weekend to sit by fireplace.
|
|
|
Sunday, February 15
|
View Page
|
 |
Only took 16 years but finally got force air from regency going upstairs.Cut heating bill at least by half.Time to frame in and finish in stone
|
|
|
Monday, February 16
|
View Page
|
 |
Received pack from RMGVG today.Thankz Wizzy!
|
|
|
Sunday, March 1
|
View Page
|
 |
Two of my test squash got snapped off today. Too many animals in this house. Glad these aren't starting line up.
|
|
|
Sunday, March 1
|
View Page
|
 |
877 hunt x self. Lone survivor. Started two more of these seeds today.
|
|
|
Friday, March 13
|
View Page
|
 |
Started some spore prints.This is a Portobello.First time growing mushrooms.Very interesting and lots to learn.
|
|
|
Friday, March 13
|
View Page
|
|
Shiitake spore prints.Hope to get some spawn jars started this weekend.
|
|
|
Friday, March 13
|
View Page
|
 |
Mycelium from Haymaker.Started in coffee grounds two weeks ago.Slow process but is growing.
|
|
|
Friday, March 13
|
View Page
|
 |
877 Hunt x open squash started March 1st.
|
|
|
Friday, March 13
|
View Page
|
 |
877 Hunt x open squash started Feb. 7th.Time to set up Grow lights and take better care of these plants.
|
|
|
Sunday, March 15
|
View Page
|
 |
Made glovebox and inoculated 4 jars of Portobello and 4 jars of shiitake in rye seed.More like a science project.One thing I'm finding out about starting mushrooms is everything must be very clean and sterile. I'll find out in 2 weeks how good of job I did.
|
|
|
Wednesday, March 18
|
View Page
|
 |
After 4 days shiitake mycelium has started one of eight jars.So far so good.
|
|
|
Saturday, March 21
|
View Page
|
 |
Shiitake mycelium went bad. Guess I wasn't clean enough.Portobello are doing good.
|
|
|
Wednesday, March 25
|
View Page
|
 |
Working north of Kaspuskasing for hydro one hauling rock 80 km to new project sight. We have to cross this dam with every load.They say one month work or until spring break up.Just want to be done by April 25 to start seeds! lol
|
|
|
Wednesday, March 25
|
View Page
|
 |
Here is picture I got from home of homemade mycorrize. The stuff sure took off in three days. Never know what you are getting when you buy this stuff and it can be pricy. At least I know this is alive and I can make lots for pennies
|
|
|
Friday, March 27
|
View Page
|
 |
Was fortunate to win door prize on BP auction. A membership with egvga. Received seed package yesterday and wow! What some great seeds!This is just making the starting line up even harder to decide this year.I really like the variety of carrot ,parsnip, rutabaga, tall corn,marrow.Things I never tried before but will this year. Thanks for having the auction Ken and thanks for the seed package Andreas! Now I just have to figure out how to get pumpkin to Europe for the weighoff! lol
|
|
|
Friday, March 27
|
View Page
|
 |
Doing so test with homemade mycro. Will start soon seeds in this mixture this weekend.
|
|
|
Sunday, March 29
|
View Page
|
 |
Started rutabagas and onions today. Grew giant onions before, first time for rutabagas
|
|
|
Wednesday, April 8
|
View Page
|
 |
My new germination chamber. Top of t.v. is the perfect temp.Trying new technic from St. Croix news letter about starting seeds.Usually I soak for one hour but these 1294 spreolex1002 kline cross were soaked for 6 hours.
|
|
|
Wednesday, April 8
|
View Page
|
|
1294 sproule x 1002 kline gotta proof read before hitting submit button. lol
|
|
|
Wednesday, April 8
|
View Page
|
 |
5.03 Lyons. I'm sure homemade inoculant is working. Plant is looking great!
|
|
|
Wednesday, April 8
|
View Page
|
|
5.03 Lyons. I'm sure homemade inoculant is working. Plant is looking great!
|
|
|
Wednesday, April 8
|
View Page
|
 |
5.03 Lyons
|
|
|
Wednesday, April 8
|
View Page
|
 |
75.2 Thomas Rutabaga.First time growing these so don't know what to expect
|
|
|
Thursday, April 9
|
View Page
|
 |
Snow today but farther ahead than resent years. Nice weather forecasted for weekend
|
|
|
Sunday, April 12
|
View Page
|
 |
Worms are active everywhere in the patch. I can't disturb them at this point so I'm going with no tilling in main patch.Broad casted rye seed today.
|
|
|
Sunday, April 12
|
View Page
|
 |
I have three covers set in place but still too wet for burying heat cables.Starting new area for two more kins so will concentrate on that for now. Itching to start my line up with the nice weather but after reading Bubbas advice came back down to earth.Will start at normal time. Still a lot of time. Thank you Mr. Parsley! Thank ya very mulch!
|
|
|
Friday, April 17
|
View Page
|
 |
Started two today
|
|
|
Friday, April 17
|
View Page
|
 |
5.03 lyons
|
|
|
Sunday, April 19
|
View Page
|
 |
Started today
|
|
|
Sunday, April 19
|
View Page
|
 |
First step...Clean empties from patch. I really gotta quit growing pumpkins.
|
|
|
Saturday, April 25
|
View Page
|
 |
Starting line up
|
|
|
Sunday, April 26
|
View Page
|
|
2102 Meier cracked open in 24 hours. Put in 6 inch pot today.
|
|
|
Sunday, April 26
|
View Page
|
|
1969 Haist is a small seed. Started soaking yesterday at 4 pm and is cracked open already. I'm starting to believe woody now that this will be an aggressive plant.This is a seed that a fluked out getting on an auction for a good price and am glad I got. I will pot it tonight
|
|
|
Monday, April 27
|
View Page
|
|
1024 Daho squash was potted this morning
|
|
|
Monday, April 27
|
View Page
|
|
I got the seed I wanted this year. 1873 Steil. Getting a bit worried...Almost 3 days now and no signs of life...yet
|
|
|
Monday, April 27
|
View Page
|
|
Gave Mr. McConkie 3 seeds today
1781 Zywiec
1756 Howell/Jolivette
1750 Martin
What the hell am I helping him for??? He's already got the Thunder Bay district record of 1411 lbs.!!!lol
True is you can't grow them all and I don't see any sense in hanging on to a seed til next year.I wish him well.
If all go right we should have the top 5 from Stillwater growing in this area this year.Nothing wrong with that.
|
|
|
Tuesday, April 28
|
View Page
|
 |
2102 Meier and 1969 Haist are the first out of the soil
|
|
|
Tuesday, April 28
|
View Page
|
 |
1840 Ghaye and 1832 Midthun both cracked open in two days. Trying my homemade inoculant on these seeds. I know this stuff is alive. No testing needed.
|
|
|
Tuesday, April 28
|
View Page
|
|
1873 Steil is a tough nut to crack.Thick shell. Not giving up yet.
|
|
|
Wednesday, April 29
|
View Page
|
|
1873 Steil has cracked open after 5 days.Was getting a little worried but I knew I'd get it.lol Now I have my starting line up and some good back ups. Germinated about 25 seeds the spring for different reasons with 100% success.
|
|
|
Wednesday, April 29
|
View Page
|
 |
This is your brain on pumpkin!
|
|
|
Thursday, April 30
|
View Page
|
 |
This house is 19 years old and never had a single mouse in it until today.This one is getting fed. She's gotta stop bringing critters home.
I was told it will be kept here til it can fend for itself then released. I heard that one before.
|
|
|
Saturday, May 2
|
View Page
|
 |
1873 Steil and 1840 Ghaye both rotted in the pot.Was sure these were both taking off but oh well...life goes on. Started a couple new back ups today and some sunflowers and corn.I really like these 21.7 Karkos. All I have left to start is long gourds.
|
|
|
Saturday, May 2
|
View Page
|
 |
1969 Haist in front and 2102 Meier are the best I have.Put in three heater cables today and soil is over 60 degrees. Shouldn't be too long and I'll have them in patch.
|
|
|
Saturday, May 2
|
View Page
|
 |
1024 Daho is my best squash and will probably get third spot in main patch. Something strange happening here. Fingers crossed.1237 Pingrey is up and looking good so time will tell.
|
|
|
Saturday, May 2
|
View Page
|
 |
Other start today
|
|
|
Saturday, May 2
|
View Page
|
 |
1247 Pingrey squash
|
|
|
Saturday, May 2
|
View Page
|
 |
1832 Midthun
|
|
|
Sunday, May 3
|
View Page
|
 |
Spring must be here. Saw first tick of the year and stapled him to the top of cold frame. Problem is he's probably still alive...Just pissed him off.
|
|
|
Sunday, May 3
|
View Page
|
 |
Heating cables are not working today but maybe that's because soil is 75 degrees 10" down. I don't really believe this but it's the same in all three planting areas.
|
|
|
Sunday, May 3
|
View Page
|
 |
Did repairs on the frames today and still have two more to build.
|
|
|
Sunday, May 3
|
View Page
|
 |
Did one hour soak of zho ,seaweed, humid acid and hair cut from tail of coon on a full moon(last night) on 1969 Haist.Everything is good...It's go time!
|
|
|
Sunday, May 3
|
View Page
|
 |
1969 Haist and 2102 Meier are both in patch. Temperatures are good, they are well covered for the night and lights for extra protection.I might be pushing it a little but weather forecast looks good.
|
|
|
Sunday, May 3
|
View Page
|
 |
2102 Meier
|
|
|
Sunday, May 3
|
View Page
|
 |
Started more melons. I have no luck with these
|
|
|
Tuesday, May 5
|
View Page
|
 |
I really like these sunflowers I got from the egvga.I started five and are starting to pop out of soil today
|
|
|
Tuesday, May 5
|
View Page
|
 |
906 Beaucheman squash. I can't figure it out but getting a lot of curly cot leaves this year
|
|
|
Tuesday, May 5
|
View Page
|
 |
Trying some different giant tomato plants this year.I have a lot to learn about growing these plants.Started 12 sweet cherry plants.Gotta eat too! lol
|
|
|
Tuesday, May 5
|
View Page
|
 |
1024 Daho squash. Best I have so far. I've seen some people having double vining with this seed. Too early to tell.
|
|
|
Tuesday, May 5
|
View Page
|
 |
968 Wuersching squash. My second best.Ireally like the colour of mama.Started the 1421 Jutras yesterday as back up
|
|
|
Friday, May 8
|
View Page
|
 |
The new Monsterdog house!
|
|
|
Saturday, May 9
|
View Page
|
 |
Always have rabbits around here but this year we are over run.Made chicken wire cages to put over plants.
|
|
|
Saturday, May 9
|
View Page
|
 |
1024 Daho in the patch today.
|
|
|
Saturday, May 9
|
View Page
|
 |
Built two new frames and put in heating cables in new patch today.I have plants ready but will wait a few days to let soil warm plus they say cold weather coming and chance of snow on Monday.Having a hard time deciding which plants get the spots
|
|
|
Saturday, May 9
|
View Page
|
 |
1969 Haist 7 days in patch
|
|
|
Saturday, May 9
|
View Page
|
 |
2102 Meier seven days in patch. Going to be frost tonight.
|
|
|
Saturday, May 9
|
View Page
|
 |
Ran out of material. Will finish tomorrow
|
|
|
Sunday, May 10
|
View Page
|
 |
My sister had a small fire to burn some debris from spring clean up.Ended up burning about 3 arces of grass,a couple of trees, the sauna and if it wasn't for the volunteer fire dept. the house would have went up too. Remember what Smokey says everyone...
|
|
|
Monday, May 11
|
View Page
|
 |
High of 4c today Low of 1 tonight -1 tomorrow. A centimeter of rain with snow mix ending tomorrow.Plants are well protected. Can't complain, happens every year.Alot better than what Colorado is getting.
|
|
|
Wednesday, May 13
|
View Page
|
 |
-6 c this morning.Plants are well covered with lights in each frame. Hoping everything is o.k.
|
|
|
Wednesday, May 13
|
View Page
|
 |
Foot prints from when I walked to patch at 7 this morning.Ground was crunchy. Hope all the buds on trees survive.
|
|
|
Wednesday, May 13
|
View Page
|
 |
Everyone survived the night. 1969 Haist. Need some sun.
|
|
|
Wednesday, May 13
|
View Page
|
 |
2102 Meier. Forecast -1 c for tonight then temps are coming up but rain for Friday thro Sunday.
|
|
|
Wednesday, May 13
|
View Page
|
 |
1024 Daho squash.Usually would have a back up beside this but I always hate deciding later on.Just have to go with this one.Hope to get rest of plants in today.Two more spots open.Another hard decision.
|
|
|
Wednesday, May 13
|
View Page
|
 |
1776 De Swert. Soaked and in patch.
|
|
|
Wednesday, May 13
|
View Page
|
 |
1421 Jutras squash in patch today also my 147 Hunt x open
|
|
|
Thursday, May 14
|
View Page
|
 |
6 sunflowers ,two 21.7 ' Karkos, two 442 cm Clemens, two 204" Nieuwenhoff
|
|
|
Thursday, May 14
|
View Page
|
 |
Added 470 Durdevic to patch. That should be it for pumpkins. This is my favourite plant. Maybe because it's the one I took least care of and is growing the best.
|
|
|
Saturday, May 16
|
View Page
|
 |
All framing is now complete.As you can see no tape measures were harmed in this project. Screws...$15 Plastic...$20 Slipping off top rung of ladder...Priceless!!
|
|
|
Saturday, May 16
|
View Page
|
|
1832 Midthun and 1651 Halverson were put in patch at my sisters house today.Glad to see my nephew is taken interest in growing again.It was 2010 when he grew a 303 lber and has not grown since.
|
|
|
Sunday, May 17
|
View Page
|
 |
Helped the Codster build two frames to cover the 1832 Midthun and 1651 Halverson.Finished just before the rain started. Lots of rain!Big system moving through.
|
|
|
Monday, May 18
|
View Page
|
 |
Expecting 10 to 15 cm. of snow an hour north of us. Lake Superior does protect us pretty good here. This is normal weather for May long.Lots of rain over night.Plants are doing o.k. ,I guess.Need some sun.I'll work in greenhouse today. Lots to do in there.
|
|
|
Tuesday, May 19
|
View Page
|
 |
Woke up to the white stuff this morning.Low of 0 c til Thursday.
|
|
|
Friday, May 22
|
View Page
|
 |
1969 Haist.Coming along. Increased potassium.
|
|
|
Friday, May 22
|
View Page
|
 |
2102 Meier. Nice stock on this plant. Not sure about yellow on the leaves.Been giving lots of nitrogen,maybe not enough. Plant is healthy other wise
|
|
|
Friday, May 22
|
View Page
|
 |
1024 Daho
|
|
|
Friday, May 22
|
View Page
|
 |
Almost finished with long gourd trellis.One more day to get it done. Leaving on Sunday for work near Emo on new gold mine.4 hour drive,gone for two weeks.Same thing every year.I'll miss the patch but my apprentice is very good.lol
|
|
|
Saturday, May 23
|
View Page
|
 |
470 Durdevic
|
|
|
Sunday, May 24
|
View Page
|
 |
1969 Haist
|
|
|
Sunday, May 24
|
View Page
|
 |
Another pic on 1969 Haist. Was leaning the wrong way but is starting to go in right direction now.I'm leaving for two weeks today so I won't be here for the landing. I'm sure everything will be fine.
|
|
|
Sunday, May 24
|
View Page
|
 |
Getting the yellowing fix on 2102 Meier.Thanks Gerald!Nice thick main starting on this plant.
|
|
|
Sunday, May 24
|
View Page
|
 |
1024 Daho. 7" wide leave.
|
|
|
Friday, June 19
|
View Page
|
 |
Been gone for 23 days working.It is hard being away for so long.Jeannine has been taking great care of the patch.This is the 1969 Haist.Growing great!Have to till in some of the winter rye and bury some vines. Leave again on Monday for two weeks
|
|
|
Friday, June 19
|
View Page
|
 |
Here is the 2102 Meier. Main split length way from landing but been down this road before and will not be a problem.Have a lot of work to do.Will post pics before I leave
|
|
|
Friday, June 19
|
View Page
|
 |
1024 Daho Squash,
|
|
|
Friday, June 19
|
View Page
|
 |
sunflowers
|
|
|
Wednesday, July 8
|
View Page
|
 |
Drove straight home after night shift on Tuesday.Pollenated this 2102 meier 12' out about 2 o'clock in the afternoon with 1969 haist.Afraid I'll have to call this an open pollination. All good.Have another about 14' which should be ready by tomorrow
|
|
|
Wednesday, July 8
|
View Page
|
 |
14' on 2102 meier
|
|
|
Wednesday, July 8
|
View Page
|
 |
12' out on 1969 Haist.It's been 14 days seen I've seen the patch but everything is good. Jeannines taking good care of everything.I guess it's not my patch any more! lol Got a lot of work to do in the next week
|
|
|
Wednesday, July 8
|
View Page
|
 |
Sunflowers are coming along
|
|
|
Friday, July 10
|
View Page
|
 |
2102 Meier day 3
|
|
|
Friday, July 10
|
View Page
|
 |
14' out on main 2102 Meier. Ready tomorrow
|
|
|
Friday, July 10
|
View Page
|
 |
1969 Haist 15' on main. Still probably 2 days away. Only female on the whole plant
|
|
|
Friday, July 10
|
View Page
|
 |
First female on 1024 Daho.14' out. Still a few days away.
|
|
|
Saturday, July 11
|
View Page
|
 |
Behind on pollination this year. This is the fifth female on 2102 Meier and second on the main. Nice five lober. This might be the one.
|
|
|
Saturday, July 11
|
View Page
|
 |
One more day for thec 1969 Haist
|
|
|
Wednesday, July 29
|
View Page
|
 |
1024 Daho squash. Self pollenated on 15th.Nice shape.
|
|
|
Wednesday, July 29
|
View Page
|
 |
2102 Meier.48inches. On same pace as my 960 lber grown last year
|
|
|
Wednesday, July 29
|
View Page
|
 |
1969 Haist. Had some seeds in the blossom but shape of kin is nice so far.Biggest I had at this time of year. 50 inches
|
|
|
Friday, July 31
|
View Page
|
 |
4 lobe on 1421 Jarvis squash
|
|
|
Friday, July 31
|
View Page
|
 |
July 30th pollination on my 147 squash
|
|
|
Friday, July 31
|
View Page
|
 |
July pollination on 1776 De swert. 3 lobe
|
|
|
Friday, July 31
|
View Page
|
 |
Got these topsy turvys for my birthday two years ago and finally used them this year. They work pretty good. Cherry tomatoes and green peppers
|
|
|
Friday, July 31
|
View Page
|
 |
Nice mega bloom on Big zac. This is all new to me so not sure what to expect.
|
|
|
Friday, July 31
|
View Page
|
 |
Another new thing this year is giant rutabaga.
|
|
|
Friday, July 31
|
View Page
|
 |
Sunflowers have been taking a beating last few days with all the wind.Hanging in there. About 8'
|
|
|
Friday, July 31
|
View Page
|
 |
1024 Daho squash. 41 cc 102 ott.Good shape, Nice blossom.
|
|
|
Friday, July 31
|
View Page
|
 |
2102 Meier.20 dap. 56 cc. 133 ott.
|
|
|
Friday, July 31
|
View Page
|
 |
1969 Haist. 19 dap. 58 cc. 145 ott. A bit behind last year,but not by much.
|
|
|
Saturday, August 1
|
View Page
|
 |
214.5 English
|
|
|
Saturday, August 1
|
View Page
|
 |
Started the process of eliminating July 20th pollination on 1969 Haist.Always hate doing this but it's go time!
|
|
|
Saturday, August 1
|
View Page
|
 |
Built shade cover for all the kins today instead of using stakes and sheets like I normally do. Haist is gaining about 10" ott. per day now. 155"
|
|
|
Saturday, August 1
|
View Page
|
 |
2102 Meier 145 ott. Plant is not the best but it's growing good.Have a lot of work left to do by Monday night when I head back to work.
|
|
|
Saturday, August 1
|
View Page
|
 |
!024 Daho squash 112 ott. Still have one growing on side vine which will be culled by Monday. I'm happy with the shape .
|
|
|
Sunday, August 2
|
View Page
|
 |
1969 Haist increased 10 inches ott. in 12 hours.will measure again at 24 hours. terminating more vines today. More burying.Plant is huge. Very healthy.
|
|
|
Sunday, August 2
|
View Page
|
 |
Rutabaga is 15 cc. Have no idea what's going on under the ground
|
|
|
Sunday, August 23
|
View Page
|
 |
Bought this weather stick yesterday which predicts weather. Up for good weather and down for bad.Thought it was a waste of 10 bucks but it actually works!
|
|
|
Sunday, August 23
|
View Page
|
 |
Rutabaga
|
|
|
Sunday, August 23
|
View Page
|
 |
.
|
|
|
Sunday, August 23
|
View Page
|
 |
Sunflowers have been through a lot this year. Nieuwenhoff is standing straight
|
|
|
Sunday, August 23
|
View Page
|
 |
1024 Daho european seed of the year 2014 is the best squash I have every grown shape wise. 220 ott.
|
|
|
Sunday, August 23
|
View Page
|
 |
2102 Meier 255 ott. 2102 meier x 1969 haist. Not as big as I'd like but I do like this cross for next year.Goal for this year is get this to 800 lbs.See what we can do.
|
|
|
Sunday, August 23
|
View Page
|
 |
1969 Haist. 299 ott. Looks like I'll be fighting to get 1000 pounder again this year. Crossed with 2102 Meier. Another good seed for next year.
|
|
|
Thursday, September 10
|
View Page
|
 |
1969 Haist .Starting to rib.
|
|
|
Thursday, September 10
|
View Page
|
 |
2102 Meier.
|
|
|
Thursday, September 10
|
View Page
|
 |
1024 Daho. 401 lbs.
|
|
|
Friday, September 11
|
View Page
|
 |
2102 Meier. 292 ott
|
|
|
Friday, September 11
|
View Page
|
 |
1969 Haist 345 ott
|
|
|
Friday, September 11
|
View Page
|
 |
Chance of frost tonight.
|
|
|
Thursday, September 24
|
View Page
|
 |
Very happy with 1969 Haist.Hope to weigh over 1000 lbs. will find out in two days
|
|
|
Thursday, September 24
|
View Page
|
 |
Tomato is ripening just in time
|
|
|
Thursday, September 24
|
View Page
|
 |
2102 Meier
|
|
|
Thursday, September 24
|
View Page
|
 |
1024 Daho
|
|
|
Thursday, September 24
|
View Page
|
 |
Another view of 1969 Haist
|
|
|
Sunday, September 27
|
View Page
|
 |
Finally got my 1000 lber. 1969 Haist weighed in at 1053 and good enough for second place.New goal is 1500.lol
|
|
|
Sunday, September 27
|
View Page
|
 |
Lorelee will be happy to know that her seed grew the new Northwestern Ontario Record.Congradulations Don!That's the last time I give a seed away! lol It's good for our club.
|
|
|
Monday, October 5
|
View Page
|
 |
First time plowing patch in ten years. I think it needed that.
|
|
|
Monday, October 5
|
View Page
|
 |
If I showed up first at this scene I'd say the strawman had something to do with it!
|
|
|
Saturday, November 14
|
View Page
|
 |
Time to harvest some seeds
|
|
|
Saturday, November 14
|
View Page
|
 |
Side view of 1053 I'm surprised it stayed together.I was worried about the blossom end but now I see how bad the dill ring was.
|
|
|
Saturday, November 14
|
View Page
|
 |
Some of the seeds from the 544 are splitting down the side. Not sure what caused this
|
|
|
Saturday, December 5
|
View Page
|
 |
Received seeds from Viginia. Thanks Hank!There are some great seeds here that will help us out a lot on our auction on Feb. 20th.I'll be sending some of our seeds to you in a week or so.
|
|

